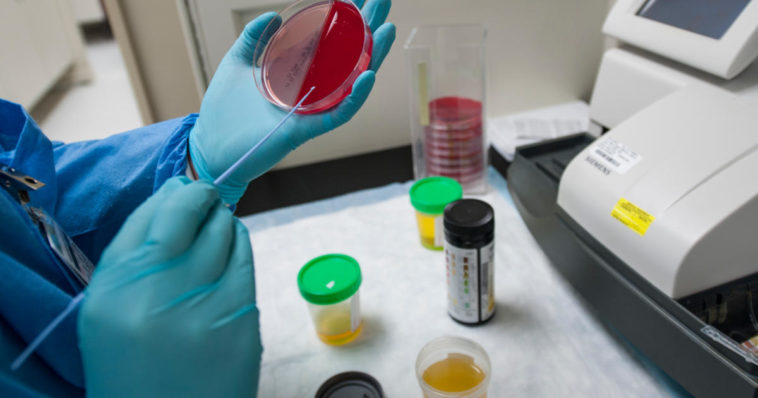
Colore della pipì in test di laboratorio medici esami delle urine

Le urine, prodotto del lavoro di filtraggio ed escrezione dei reni, possono assumere diverse gradazioni di colore e rivelare informazioni sul nostro stato di salute. Il colore della pipì dipende da quanta acqua abbiamo bevuto, ossia dal nostro stato di idratazione, ma anche dagli alimenti o da medicine che abbiamo introdotto nel nostro corpo. Altre volte il suo colore può essere un campanello d’allarme e segnalarci seri problemi di salute.
Se la pipì è trasparente, incolore, allora significa che stai bevendo troppa acqua: sebbene bere tanta acqua è consigliato, berne troppa può recare danni al nostro organismo. Se le tue urine non hanno alcun colore forse è il caso di bere un po’ di meno.
Se il colore dell’urina è invece giallo paglierino chiaro, giallo trasparente o giallo scuro, non hai motivo di preoccuparti. Questo è il range di colori all’interno del quale l’urina è considerata normale. Semplicemente cerca di bere un po’ di più se è di colore giallo scuro, un po’ di meno se è giallo trasparente.
Dovresti iniziare a preoccuparti e bere di più se la tua urina è di colore ambra o giallo mela. Questo è un messaggio esplicito del nostro corpo che ci invita a bere di più!
Se la tua pipì è marrone faresti bene a consultare un medico: questo colore può indicare un grave stato di disidratazione o problemi al fegato.
Se la pipì è rosa oppure rossa potrebbe essere dovuto semplicemente ad alcuni alimenti che hai ingerito. Rabarbaro, mirtilli, more, rape, barbabietole, sono alcuni degli alimenti che possono colorare di rosso l’urina. Se invece non hai mangiato questi alimenti il colore rossastro potrebbe essere dovuto ad una presenza di sangue nelle urine, ad infezioni delle vie urinarie, malattie renali, problemi alla prostata, tumori o altro. Tra le opzioni anche un avvelenamento da mercurio o piombo. Anche in questo caso contatta il medico.
La pipì arancione può essere sintomo di patologie al fegato o problemi al dotto biliare, oppure segnale di una scarsissima idratazione. Alimenti che possono causare una variazione del colore dell’urina tendente all’arancione sono le carote o altri cibi ricchi di vitamina C.
Se la pipì è blu potresti avere un’infezione batterica, oppure hai assunto farmaci contenenti blu di metilene. L’urina blu può essere sintomo della sindrome del pannolino blu o di ipercalcemia.
Se la pipì è di colore verde forse hai mangiato troppi asparagi. Se così non fosse l’urina verde potrebbe indicare, come nel caso precedente, infezioni del tratto urinario o può essere causata dall’assunzione di alcuni farmaci.
L’urina nera, invece, potrebbe essere sintomo di malattie come l’alcaptonuria o di un melanoma maligno.
Se la pipì invece è schiumosa potrebbe essere semplicemente un occasionale effetto della pressione “idraulica” nell’impatto con l’acqua del water. Se ciò avviene invece in maniera sistematica potrebbe indicare un eccesso di proteine nella propria dieta o problemi renali.